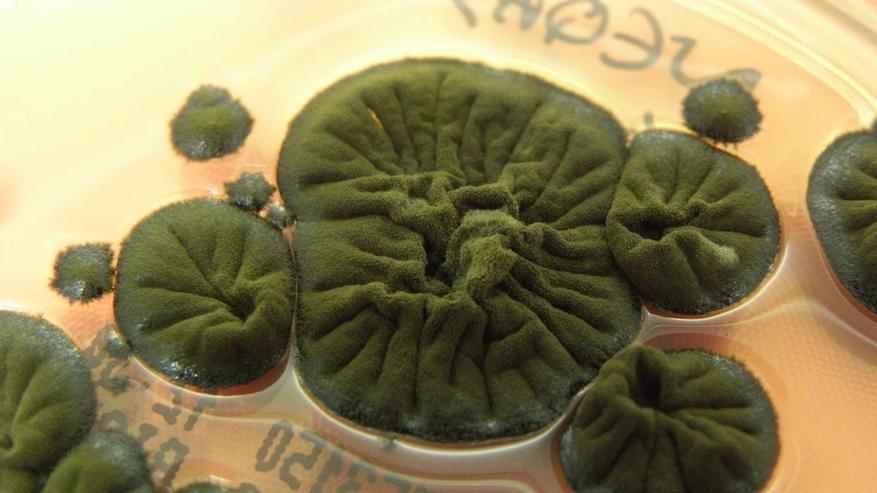

Грибок из Чернобыля выработал способность выживать за счет радиации
Спустя 40 лет после аварии на Чернобыльской АЭС ученые обнаружили внутри разрушенного четвертого энергоблока популяцию черных грибков Cladosporium sphaerospermum, которые не просто выживают в условиях экстремального облучения, но и используют его для роста. Исследователи предполагают наличие процесса «радиосинтеза» — способности меланина захватывать ионизирующее излучение и преобразовывать его в энергию, подобно хлорофиллу при фотосинтезе.
Эксперименты показали, что радиация не повреждает ДНК грибка, а стимулирует его развитие. В 2022 году образцы C. sphaerospermum тестировали на внешней стороне МКС: слой грибка успешно поглощал космическое излучение, действуя как живой щит. Несмотря на то, что точный биохимический механизм усвоения радиации пока не подтвержден в лаборатории, способность организма процветать в смертельной для человека среде открывает перспективы создания биологической защиты для космических миссий.
Источник: ScienceAlert











0 комментариев
Добавить комментарий